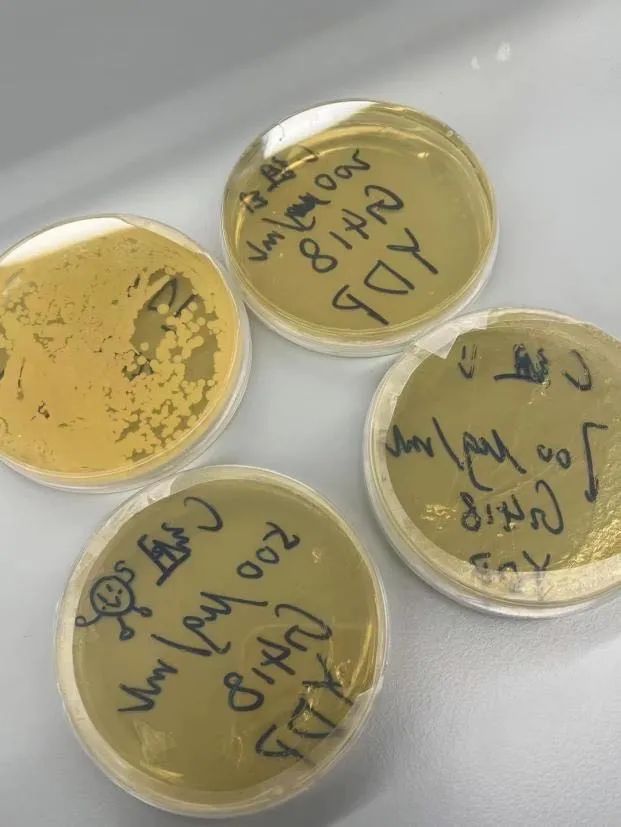

深圳高级中学国际课程体系iGEM国际大赛斩金夺银

基因工程,国际大赛
国际基因工程机器大赛,英文名称为International Genetically Engineered Machine competition,简称iGEM。
国际基因工程机器大赛是合成生物学领域的国际顶级高中生科技赛事,也是涉及数学、计算机、统计学等领域交叉合作的跨学科竞赛。由美国麻省理工学院于2003年创办,2005年发展成为国际赛事。国际基因工程机器大赛赛况和研究成果每年都受到《科学》、《自然》、《科学美国人》、《经济学人》等顶级学术杂志、英国广播公司的关注并进行专题报道,具有广泛的国际影响力。

2023年iGEM比赛于11月1日至11月5日在巴黎举行,2023年参加iGEM的队伍数量达到了395支,每支队伍从三月份便开始了他们的合成生物学之旅,为解决世界上重大问题提供解决方案。每支队伍从需要Environment(环境),Climate Crisis(气候问题),Bioremediation(生物修复),Conservation(生物保护)、Agriculture(农业),Food & Nutrition(食品与营养),Foundational Advance(基础性建设),Biomanufacturing(生物制造),Therapeutic(治疗),Diagnostic(诊断)十个主题中至少选择其一作为研究题目。每支队伍需要集结队员,在大学实验室完成实验部分,并且为自己的项目创建Wiki,完成Design(项目设计方案),Part(基因序列)等内容的全英文写作部分并且上传至Wiki。十一月份每支队伍将会有代表成员前往巴黎参加Jamboree,代表队伍完成Team Booth(队伍交流)和Presentation(项目主要内容展示)的任务,最后参加Judging Session(答辩)的环节,而在答辩环节没有前往巴黎的队员将会线上参与。
蟾宫折桂,深高佳绩
经过层层筛选,激烈角逐,深圳高级中学(集团)国际课程体系的学子在iGEM斩获Medal Prizes:一金一银,Special Prizes:一项获奖,五项提名,Finalists:Top 10 High School Team的优异成绩。

高二IB班付宇扬同学和高二AL班付亦农同学所在的队伍“Nanjing-SDG”获得高中生组Finalists TOP 10、全球银奖、Best Wiki 提名、Best New Improved Part 提名、Best Part Collection 提名、Best Presentation 提名。

高二IB班曹桐嘉同学所在的队伍“Hangzhou-BioX”获得全球金奖、Best Part Collection获奖。

奖项说明:
1. Finalists:由评委通过综合评价每支队伍的实验内容、实验结果、提交的论文,以及答辩表现等,所给出的综合奖项,此奖项为队伍和队伍之间的比拼。
2. Medal Prizes:和我们熟知的金银铜奖项不同,Medal Prize只需要参赛队伍完成特定的固定任务,达到特定标准即可获奖。
3. Special Prizes:此奖项颁给队伍某一个特定部分的成果,例如网页制作。
立足当下,世界眼光
高二IB班 曹桐嘉:
项目介绍:
我们团队进行了大量的文献收集和线下调研,发现全球大多数人口缺乏维生素B2的补充,尤其是在中国,男性维生素B2缺乏率高达88.1%,女性则高达85.4%,而且在我们收集的1169份线上问卷中,我们发现只有19%的人知道维生素B2的每日推荐摄入量,39%的人知道维生素B2缺乏导致的症状,以及全球大概有39%的人们从未服用过维生素B2补充剂,我们从问卷的结果中了解到人们对维生素B2对人体的重要性并没有足够的意识。因此,我们决定在面包酵母Saccharomyces cerevisiae中过表达GTP合成酶—ADE4和维生素B2合成酶—RIB1和RIB7,以提高维生素B2在面团中的产量。通过过表达面包酵母中的GTP合成酶(ADE4)和维生素B2合成酶(RIB1和RIB7),我们希望能够让大家认识到维生素B2对于人体的重要性和必要性,同时解决人们有效补充维生素B2的问题,为人们的健康提供更多保障。
iGEM看似是一群高中生聚在一起,穿着白大褂讨论学术问题,但实际并非如此,iGEM其实是一个需要接受实验反复失败和强迫高中生被别人鸽的比赛。
作为队长,我尝试了很多“第一次”,从今年年初开始学习文献阅读,组织队员们准备wiki内容,七月份初次踏入浙大实验室进行为期一个月的实验,第一次尝试网站和promotion video的制作,和队友奔赴法国巴黎的Grand Jamboree进行team booth和judging session。在现场答辩环节中,最后一位裁判在我面前两次提出了对我们队伍项目价值的质疑,尽管我们团队在最后1分钟通过展示问卷数据和自制的网站证明了人们并没有服用维生素B2营养品的意识以及改造后的面包酵母所产生的维生素B2含量会比普通面包多将近一倍,我走出judging room的时候情绪还是比较低落,认为最后一个问题的回答并不是很完美,因为那位裁判的神情显然认为我们的回答没有说服力,但最终还是获得了全球金奖和Best Part Collection单项奖,这种释然和成就感是我前所未有的。

这些成就的达成是指导老师们悉心教导和我们团队共同奋斗克服困难的结果,也是我作为学生个体在此次比赛中不断成长的见证。iGEM充分锻炼了我的综合能力,希望SID以后会有越来越多的同学成为出色的iGEMer。
“付付得证”,共攀高峰
高二AL班 付亦农

项目介绍:
传统能源日益枯竭和温室效应对全球可持续发展构成挑战。丁酸丁酯的低粘度和低碳排放使其成为一种极有潜力缓解上述问题的生物燃料。我们对C. tyrobutyricum进行了基因工程改造,使其能够高效、大规模地合成丁酸丁酯。我们通过前体积累、抑制副产物、提高传质效率和启动子三种策略优化代谢途径,进一步促进丁酸盐和丁醇的合成。

从四月到十一月;从深圳高级中学,到南京工业大学,再到巴黎Jamboree现场,一路上历尽艰辛,但是最终苦尽甘来。回头看去,轻舟已过万重山,登顶之路上我始终忘不了和 高二IB付宇扬的默契合作。项目开始时,我们面临着论文不会写,文献不会查,项目看不懂的窘境。但是在一个个晚自习和线上会议的讨论中,我们深究反应机理,代谢路径,以及实验内容,查找了百篇论文,努力为最重要的线下实验部分做好准备。七月,我和付宇扬共赴南京,在南京工业大学的实验室耗期一个月完成了大部分实验内容,在一次次的失败和考验中,我和付宇扬配合默契,我制作培养基,他负责电泳胶。我来结合质粒,他来检测浓度。我们经历过用了20个小时配出的质粒最终报废的崩溃;也经历过重复多次实验但是最终浓度过低,导致没有实验价值的尴尬。但是在对实验的一次次打磨一次次修改实验操作之后,我们也终于在规定日期前将所有项目成果提交至赛事组。
十一月初,队伍中仅我和付宇扬两人前往巴黎参加线下答辩,去应对最后的挑战。在巴黎付宇扬总说我是队伍的“大腿”,其实不然,没有教授、指导老师、大学学长支持,我自然也不可能取得好成绩。当付宇扬的一路相伴,配合默契,心心相印,无时无刻给予我坚持下去的动力。我们一起在最后的Presentation环节共同向评委展示了最终成果,而最终的结果也没有辜负我们的努力,为全队大半年的努力画上完美句号。
最后我也感谢每一个默默支持我,鼓励我,给我信心的家人和朋友们,是你们支撑着我站上iGEM的领奖台!
自强不息,扬帆起航
高二IB班 付宇扬

参加iGEM的路上,无论是四月到六月的校内自主学习,七月前往南京工业大学的线下实验,还是十一月远赴巴黎参加jamboree,我在每一个阶段都获益匪浅。刚进入队伍时,我便感觉压力山大,因为要应对老师安排的有关基因工程和分子生物学的高难度课程。因此,我常常与队友@高二AL付亦农 一起学习并探讨,也常向生物老师询问相关知识,逐步地提升了自己对于新知识的接受和理解能力。

在南京工业大学进行线下实验时,我学习并使用了许多未曾见过的仪器。从一开始的双手发抖,到最后的稳拿稳放,我对于自己的实验操作更加自信。虽然实验中我和队友也遭遇了不少的失败,比如制作的培养皿不小心染菌,制作的质粒因为放错位置导致报废······但是我依旧在实验中学习到了很多东西,不仅仅是基本的实验操作,实验规范,还有对待实验应有的耐心,细致,以及接受失败,不气馁的心态。最后一站,我前往巴黎参与全球线下jamboree。
在巴黎,我们向全球各地的选手介绍我们的项目。除此之外,我还和付亦农配合完成了一个presentation,向裁判,评委和其他选手介绍我们的项目。尽管我们都十分紧张,但是我们凭借着对于自己项目的信心,顺利地完成了展示。在最后的judging环节,我要感谢我的队友付亦农。他对于我们项目的足够熟悉,使他能够流利地回答出几位judge的各种刁钻问题。
最后的结果没有辜负我们大半年的努力,一切都得到了最好的结局。同时,我也感谢每一个帮助过我的教授,老师,学长,同学以及每一个给予我支持和力量的家人和朋友们,我的IGEM之路离不开你们的鼓励与支持。

*综合内容来源学校,如有不妥,请告知.





 想请问学校的入学评估的考试内容有哪些?
想请问学校的入学评估的考试内容有哪些?
 请问学校有提供校车服务吗?
请问学校有提供校车服务吗?
 HKDSE主要招几年级的?
HKDSE主要招几年级的?
 高中部有多少学生
高中部有多少学生
 有寒假课吗?或网课
有寒假课吗?或网课




